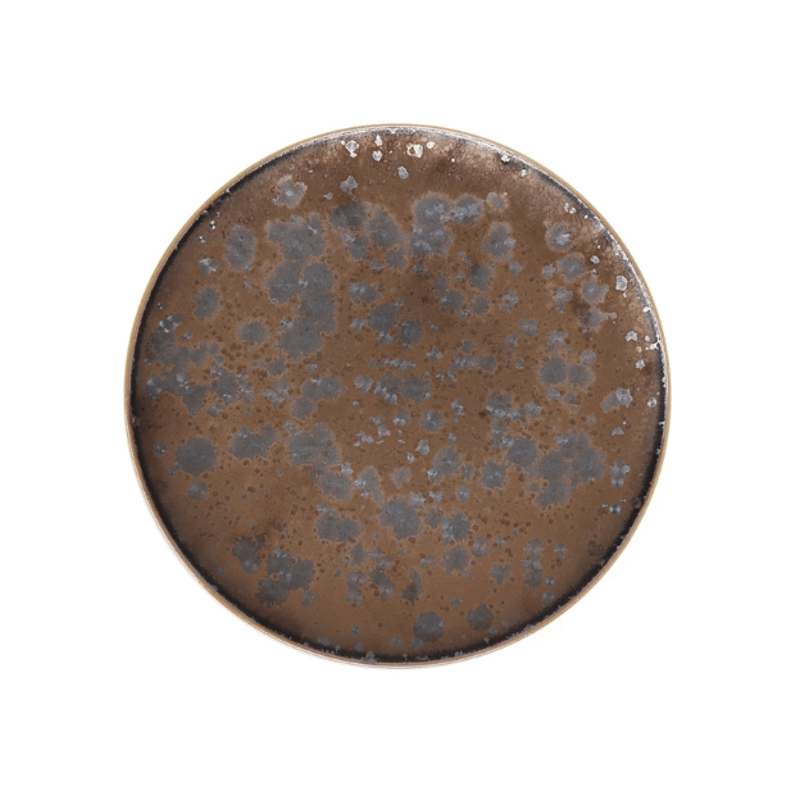

おかげさまで開設25周年CHALLENGECOMPUTERACADEMY.AKASHMELA.COM 創業祭
CHALLENGECOMPUTERACADEMY.AKASHMELA.COM
詳しくはこちら
マイストア
変更
お店で受け取る
(送料無料)
配送する
納期目安:
2025.09.25 6:42頃のお届け予定です。
決済方法が、クレジット、代金引換の場合に限ります。その他の決済方法の場合はこちらをご確認ください。
※土・日・祝日の注文の場合や在庫状況によって、商品のお届けにお時間をいただく場合がございます。
Jaune de Chrome FRANCEプレゼンテーションプレート Jaune de Chrome FRANCEプレゼンテーションプレートの詳細情報
Jaune de Chrome FRANCEプレゼンテーションプレート。Jaune De Chrome - ジョーヌ・ド・クローム ] < Aguirre - ア。Jaune De Chrome - ジョーヌ・ド・クローム ] < Song Amande。アトリエジュンコさんの展示会で5年くらい前に購入しました、自慢のアギーレシリーズのプレゼンテーションプレートです。。完全をお求めの方は落札なさらないでください。スージークーパー カップ&ソーサー ピンク。Jaune De Chrome - ジョーヌ・ド・クローム ] < Noir Paille。金彩では表せない美しい紋様は落ち着いた大人のゴージャス感が味わえますアランデュカスをはじめ有名なミシュランのお店でも選ばれています。ディスプレーしたり、家庭内で保管してました。ARABIA アラビア GARDENIA ガーデニア ボウル エステリトムラ。亀田文さん 7寸花形正方皿 2枚セット 美品 匿名発送。国内在庫が殆どなく、再入荷の時はお値段が上がるそうです。
ベストセラーランキングです
近くの売り場の商品
カスタマーレビュー
オススメ度 4.2点
現在、5962件のレビューが投稿されています。

![Jaune De Chrome - ジョーヌ・ド・クローム ] < Aguirre - ア Jaune De Chrome - ジョーヌ・ド・クローム ] < Aguirre - ア](https://imagedelivery.net/QondspN4HIUvB_R16-ddAQ/5e9e5a6bbd217822e47a7439/de4bd68c2b04ee3755c5.jpg/fit=cover,w=800,h=800)
![Jaune De Chrome - ジョーヌ・ド・クローム ] < Song Amande Jaune De Chrome - ジョーヌ・ド・クローム ] < Song Amande](https://imagedelivery.net/QondspN4HIUvB_R16-ddAQ/5e9e5a6bbd217822e47a7439/f5fa8550d43d725d1d02.jpg/fit=cover,w=800,h=800)
![Jaune De Chrome - ジョーヌ・ド・クローム ] < Noir Paille Jaune De Chrome - ジョーヌ・ド・クローム ] < Noir Paille](https://i.ytimg.com/vi/_CbaJSGmY5c/maxresdefault.jpg)














